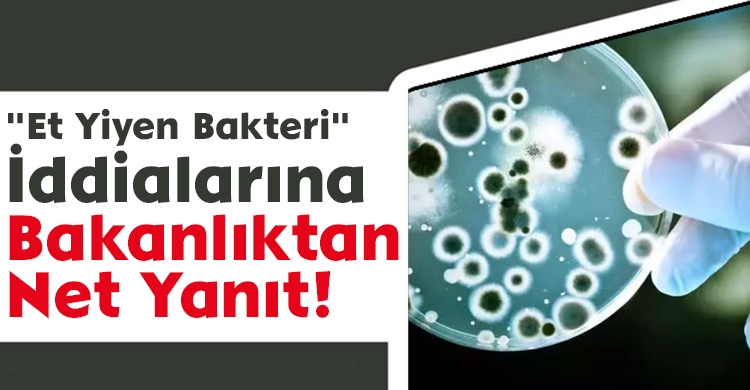

Sosyal medyadaki iddialar sonrası Sağlık Bakanlığı harekete geçti. 2025 verilerine göre Türkiye'de bu bakteriye rastlanmadı.
Sağlık Bakanlığı, bazı sosyal medya platformlarında yayılan "Vibrio vulnificus" yani halk arasındaki adıyla et yiyen bakteri iddialarına yanıt verdi.
Halk Sağlığı Genel Müdürlüğü, 2025 yılı verilerine göre Türkiye’de bu bakteri kaynaklı hiçbir vakaya rastlanmadığını duyurdu.
Yetkililer, bakterinin ılık ve tuzlu sularda yaşadığını, açık yaralardan vücuda girebildiğini ve çiğ deniz ürünleriyle bulaşabileceğini belirtti. Bağışıklık sistemi zayıf olanlar için risk daha büyük.